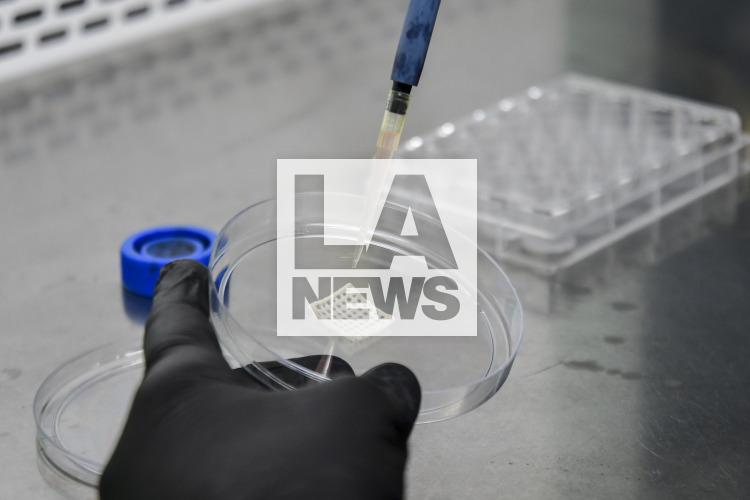
imagen principal

November 30, 2022
Buenos Aires,Argentina
2738 x 1825 px
November 30, 2022
Buenos Aires,Argentina
2738 x 1825 px
Buenos Aires, Argentina.- In the photos taken on November 29, 2022, scientists from the Faculty of Pharmacy and Biochemistry of the UBA (FFyB) and the Conicet developed a bioink that contains cannabis oil for 3D printing that can be used in the regeneration of tissues or restoration of damaged organs, which is a novelty worldwide due to the use of the derivative of this plant with antimicrobial and antioxidant properties, among other benefits, in addition to being biocompatible.
TagsAmerica , , Argentina , Buenos Aires , cannabis , medical cannabis , Latin America